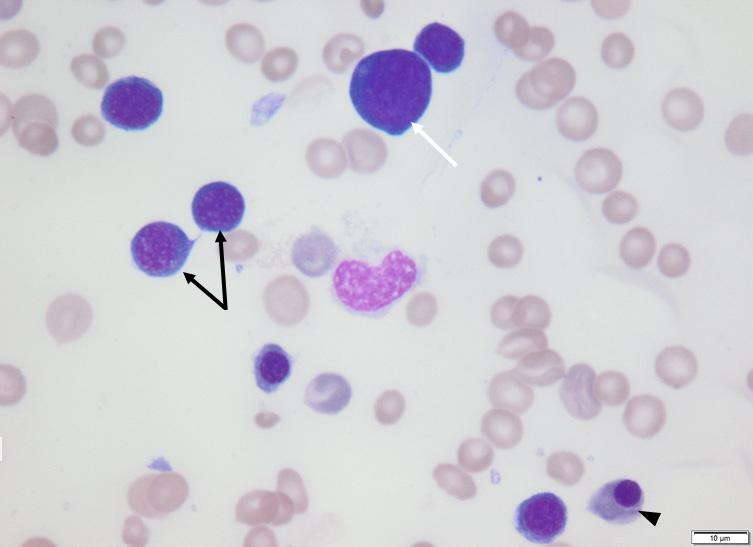

Dr Man-hei Ma BSc(PV), DVM, GCertSAUA, MANZCVS (Small Animal Radiology) RVA President
Dr Man-hei Ma BSc(PV), DVM, GCertSAUA, MANZCVS (Small Animal Radiology) RVA President

At the start of 2022, when I stepped in as President of the University of Adelaide Roseworthy Veterinary Alumni, I gathered the RVA committee together to brainstorm ideas on how we could build and connect our Alumni community. The key focus of these ideas were to grow the RVA in areas that would support Veterinary graduates of the University of Adelaide in all facets of our veterinary profession including evidence-based medicine, mental health, professional advice, mentorship, and the ongoing collaboration between the University and their alumni. Throughout the year we have brought several of these concepts to life with more currently in development quietly behind the scenes; and I look forward to seeing these seeds come into fruition for you all in the near future.
As the president of the RVA and on behalf of the committee, I am proud to present to you, our readers, our very first issue of “Newsworthy”.
Our vision was to create a newsletter which brought pages of clinical and research news from all industries of our profession, mental health advocacy, stories happening on campus, and stories from alumni career journeys which will inspire your own goals and dreams to become attainable to you in your own unique way. In this issue we also bring to you an introduction to our committee members, an insight into the RVA’s motif, a fun ‘Wine and Dine’ section for you to enjoy post-work, and this year’s RVA South Australian Workforce Survey.
This newsletter is only made possible with each guest contributor who has written articles that make up these 40 odd pages – we are very humbled and grateful for their time in sharing their knowledge with us. A conscious decision was made to ensure that every person who have and will pencil words for Newsworthy are alumni, present or former professors, associate professors and lecturers at the Roseworthy Veterinary School. As such we welcome any of you to reach out to us to feature as a guest contributor to the newsletter.

Undoubtably, as the Roseworthy Veterinary Alumni community grows each year with new graduates joining us, I can only imagine the pages of Newsworthy to evolve and grow as well. It excites me to hear, read and see how each of our graduates go on to build fascinating and successful careers all around the world; and I look forward to reading about it in the years to come.
In the meantime, enjoy Newsworthy’s first issue! Myself and the committee welcome your feedback and suggestions on what you, as our readers, would like to see.
Copyright © 2022. RVA. All rights reserved.
Copyright © 2022. RVA. All rights reserved.
Manhei Ma is a 2014 graduate, has furthered her studies in diagnostic imaging, and worked interstate and overseas for several years before returning to Australia and founding SonoVet, a mobile diagnostic imaging service.

She is our newly appointed president and is excited to lead and work with the committee in building an engaging program for the RVA community, maintaining the ongoing connection between alumni and the University of Adelaide, as well as striving towards our network’s aim of ‘mentoring, engagement, advocacy and support to students and alumni’.
Wayne or Boarders as he is often known, feels truly privileged to have had many adventures as a zoo and wildlife vet and fortunate and grateful to be an academic and researcher at the University of Adelaide. He genuinely enjoys other people’s successes and being able to share things he has learnt on the train journey of life so you don’t make the same mistakes as he did. He plans to continue encouraging and advocating for students, alumni and the conservation of biodiversity until he has outdone is welcome on this Earth.
Mary McQuillan graduated from DVM in 2016. Mary is a mixed animal veterinarian and is the principal investigator on the 2019-2021 “Unlocking the keys to ewe survival”, Meat and Livestock Australia (MLA) funded project. Mary is also a research associate with Charles Sturt University (CSU) and is currently undertaking a professional doctorate at CSU with the expected completion at the end of this year.


READ RESEARCH NEWS Pg32

“Ewe Survival Research”
Mary is passionate about keeping our graduates connected and advocating for our profession. She looks forward to connecting with you at our upcoming events.
Carolyn McLean was the Alumni Relations Officer at the University of Adelaide since 2017 where she assisted in the creation of the RVA network. This year was her final year working with the Alumni Relations and thus ends her work with our network.
Matt Bell mid year stepped in as the new Alumni relations officer. He is an alumnus of the University of Adelaide, having studied Civil Engineering and Finance as an undergraduate. He comes to the University’s Alumni team after three years as a committee member of the Young Alumni Network. As an Alumni Relations Coordinator, Matt’s focus will be on the Faculty of Science, Engineering and Technology. He is looking forward to supporting the development of all alumni networks, including the RVA.
Copyright © 2022. RVA. All rights reserved.

Liz Napier is a 2014 graduate who after working in mixed practice decided to make the jump into Emergency and Critical Care in Newcastle, NSW. After realising working with critically sick and injured pets was her passion, she continued to expand in her role as team leader. Liz provides support and mentoring to the ER vet team and internship programs, and loves seeing the development of vets during their career path.


Mental Health is such an important part of our profession, and Liz is excited to work with the committee and alumni to increase Mental Health awareness and education. Liz is a certified Mental Health First Aid instructor, equipping veterinary professionals with the skills to be certified Mental Health First Aiders.
Angus Misan graduated in 2018 and has been a general committee member of the RVA since its inception in 2019. He has worked in mixed practice on the Fluerieu Peninsula since graduation, and enjoys the variety of work that mixed practice entails.
Angus joined the committee in 2019 because he appreciated the importance of maintaining contact with his uni peers and mentors, and saw the value in a network focusing on those aspects. He hopes that as the RVA grows over the years, Alumni are provided with increasing opportunities to catch up, network and support each other.
Mitchell Graham graduated from Roseworthy in 2020 and has started his career working in small animal general practice. After being involved in many committees while at uni striving to make positive change for students, Mitchell was thrilled to join the RVA. He will be a general committee member this year and is looking forward to bringing the recent graduates into the fold. Mitchell is excited to contribute to the many engaging initiatives and events that the committee has planned for this year and will start by performing a South Australian/ Roseworthy version of the recent AVA workforce remuneration analysis.
Emma Maley is a new graduate having completed her studies in 2021. She has recently started her new job and is looking forward to a long career in veterinary medicine.

She is a general committee member and is excited to bringing a new graduate perspective to the role. She’s looking forward to being involved with the projects we have to come and can’t wait to share them with you.



Daniel McGilp graduated in 2018 and worked for 3 years in a mixed (mainly companion) practice based in Mount Barker. He has now followed his passion and started a residency in Veterinary Pathology based at The University of Queensland.
Daniel has been part of the RVA committee since 2019. His aims are to help graduates find the support and guidance they need to build the life and career they want.
Emma Vermeeren graduated in the inaugural class of 2013, and was the founding President of the Adelaide Veterinary Students Association (AVSA). She enjoyed several years of general mixed practice after graduation (including 6 months at her parents’ practice on Kangaroo Island), whilst also pursuing her passion of dog training and veterinary behavioural medicine. Emma now works solely in her own veterinary behaviour and dog training business, Animal Behaviour Coaching, located in the rural town of Keith, SA. Emma attained her MANZCVS (Veterinary Behaviour) in 2021 and is mum to 2 young children, Hallie and Thea.
Emma has been a general committee member of the RVA since its inception, and is looking forward to continuing and expanding the events, CPD, networking and support RVA offers.

Claire MacRae graduated from Roseworthy with the inaugural class of 2013, and quickly moved into small animal emergency medicine and hospital management. She has worked in and led multiple emergency and critical care departments, including at the Companion Animal Health Centre at Roseworthy, and has spent several years teaching Cert IV nurses at TAFE and DVM and Vet Technology students at the University. Claire is the owner of veterinary telehealth business OnlineVet, and solo Mum to toddler Piretta. As the founding and outgoing President of the RVA, Claire is excited to see the venture develop and grow in its capacity to provide support, mentorship and continuing education to its members and the wider veterinary community.

Michelle Lloyd is a 2015 graduate from The University of Adelaide. She came from a background working in physiology research and developed a love for the animal work involved. Since graduating she has worked in small animal general practice, enjoying the challenges and diversity it brings. Michelle’s passion is for feline medicine but she also loves teaching and sharing her knowledge. Michelle has been involved in tutoring and teaching subsequent Roseworthy students since graduation.
She looks forward to helping support fellow graduates and the veterinary profession as a whole as a member of the RVA committee.
Copyright © 2022. RVA. All rights reserved.
BSc, DVM, MSc, DACVP (Clinical Pathology)
Peter graduated from the DVM program at the University of Adelaide in 2014. After three years in small animal practice, he was accepted into a clinical pathology training program at the University of Saskatchewan in Saskatoon, Canada. He became a diplomate of the American College of Veterinary Pathologists in 2021 and moved back to Adelaide. He currently works at Gribbles Veterinary Pathology and at the University teaching DVM students. His professional interests include diagnostic cytology and exotic animal clinical pathology.

BVSc, BSc(Vet), PhD, MANZCVS(Animal Welfare), GradCert(Public Health), GradCert(Higher Education)
Since 2006 Susan has taught animal behaviour, welfare and ethics in the School of Animal & Veterinary Sciences. Susan is the Program Coordinator for the BSc(Animal Behaviour), on the Boards of the Dog and Cat Management Board and RSPCA SA and a member of the Animal Welfare Advisory Committee of SA and the Animal Wellbeing and Welfare Committee of WSAVA. She works with an incredible group of academics and students in the Animal Behaviour Welfare & Anthrozoology Lab (ABWAL, https://www.abwal.com/).

DVM, MS, DACVIM (Neurology) Assistant Professor of Neurology & Neurosurgery Department of Clinical Sciences, Auburn University College of Veterinary Medicine Dr. Devathasan is an Assistant Professor of Neurology & Neurosurgery at the Auburn University College of Veterinary Medicine. He received his DVM from the University of Adelaide. Following graduation, he undertook a rotating internship at Queensland Veterinary Specialists followed by a surgical internship at the Centre for Animal Referral and Emergency in Melbourne. He subsequently completed a three-year residency in Neurology and Neurosurgery at Purdue University through which he also earned his master’s degree. His current research focuses on neurosurgery and cerebrospinal fluid disorders.

BSc, BVMS (Hons), PhD, MANZCVS, DipACVP (Anatomic)
A/ Prof Veterinary Pathology, The University of Adelaide.
Lucy is a specialist veterinary pathologist at the University of Adelaide and Vetnostics, Sydney. Lucy’s research interests include health and conservation of terrestrial and marine mammals, as well as the impact of anthropogenic activities (i.e. us!) on wildlife health and welfare.



BVSc (Hons), PhD
Tamsyn is a veterinarian for Adelaide Koala and Wildlife Centre, Literature Reviewer with the Koala Health Hub, University of Sydney on the National Koala Disease Risk Analysis Project, occasional pathology tutor for DVM3’s and Adjunct Lecturer at Adelaide University. Tamsyn’s research interests include wildlife survivability after rehabilitation, marsupial health and disease.

BSc (Pre- Vet), DVM, MANZCVS (Int. Med)
Abi is a graduate of the Adelaide University 2014 DVM Cohort. She is a Small Animal Internal Medicine Registrar, working at Peninsula Vet Emergency and Referral Hospital on the Mornington Peninsula, Victoria. She enjoys all aspects of the challenges of Internal Medicine, with a particular interest in atypical infectious disease (which seem to be quite prevalent on the Peninsula!).
Outside of work, Abi is a keen (some would say obsessed) marathon runner, lover of live music, and parents two cats – Yeti and Mintie.
MVM, DVM, PhD, Dip RDVS, Dip ECEIM
Lidwien obtained her Doctor of Veterinary Medicine (DVM) at Utrecht University, The Netherlands, in 1996 and qualified as a Diplomate of the European College of Equine Internal Medicine. Her focus on equine medicine led to 8 years of valuable experience with Arab and high-performance horses in Jordan and Kuwait where she developed an ongoing interest in their thermoregulation. Since 2011, she has held tenure as a Senior Lecturer in Equine Medicine at School of Animal and Veterinary Science and contributed significantly to the development of the new School. In July 2022, she completed her PhD on thermoregulation during exercise as the first joint-PhD with two degrees from the University of Adelaide and Ghent University, Belgium, which is 1st Shanghai ranking since the last 6 READ RESEARCH NEWS Pg 34
Copyright © 2022. RVA. All rights reserved.
Connecting with our alumni across Australia and the world.
Our Roseworthy Veterinary Alumni (RVA) Network aims to nurture the relationship between the University of Adelaide, our veterinary alumni and members of the public through engagement, mentoring, advocacy and support to students and alumni.

Some of the committee’s key objectives are:
• Support ongoing evidence based veterinary medicine and advocacy
• To promote mentoring opportunities and provide careers and professional advice for alumni and students
• Be a representative body for veterinary scientists in South Australia
• To support alumni in times of need through links to mental health and other resources
• Organise and host events promoting the RVA Network
• To promote the interests of The University of Adelaide’s Roseworthy campus and the School of Veterinary and Animal Sciences (SAVS)
• To encourage discussion in all facets of veterinary science including, but not limited to; policy, veterinary public health and associated research






The colours of pink and navy pay homage to the traditional Roseworthy Campus colours of pink and black, originating from the campuses time as an agricultural college for over a century.


The white ‘V’ in the centre is in line with many of the Veterinary schools around the world that have the ‘V’ for ‘veterinarian’ in their logos.

The Southern Hairy Nosed Wombat is South Australia’s mammalian faunal emblem, and is significant to the University of Adelaide, as the species diggings led to the discovery of the copper belt across the Yorke Peninsula. Some of the large fortune generated by Walter Watson Hughes was bequeathed in 1872 to help build the University.

The secondary motif features the goals of the Roseworthy Veterinary Alumni Network, which aims to nurture the relationship between the University of Adelaide, our veterinary alumni and members of the public through engagement, mentoring, advocacy and support to students and alumni.


The circular hand represents us, the alumni as veterinarians, as guardians and custodians of all animals, with the four animals chosen to represent all the animals we work with; equine, ruminant/production, companion and wildlife.




Your mental health is a combination of your psychological and emotional well-being, and impacts your daily mood, activity levels and physical health. Your mental health allows you to cope with the normal stresses of life, so you can work productively and contribute to the community.
Unfortunately, many of us have experienced first-hand the impact of mental illness on our profession and the loss of life this can result in. Many of us have read and heard the figures regarding Mental Health and the impact it is having on veterinarians. This is why it is so important for the veterinary community to talk about mental health, while advocating for and supporting each other.
Many of us identify stress as a part of being a veterinarian. Within the many different roles we can have in the profession we can have days where we are having to adjust hour by hour with what is being asked of us.
Liz is an emergency veterinarian with a passion for mental health in the veterinary profession. After seeing the impact of mental illness within the profession Liz wanted to expand her knowledge in this area, while also being able to provide support and information for colleagues and clients.


In 2020 Liz became a certified Mental Health First Aid Instructor, and has since been teaching mental health first aid to veterinary professionals.
So what does stress have to do with mental health, and why is it important?
Chronic, unmanaged stress can lead to reduced mental health, and can exacerbate mental illnesses such as anxiety and depression. Likewise, stress management can lead to improved mental health and a reduction in deterioration of mental illness.
It is important to acknowledge that stress can be useful as it is our ‘fight or flight’ response –increasing our adrenaline when we are in danger. However, where it can be detrimental is when we have prolonged or chronic stress that is not managed. This is where we can see a change in ourselves both mentally and physically including signs of fatigue, irritability, reduced self-care, reduced joy in activities you usually enjoy and changes in sleeping and eating habits.
We have all experienced that feeling of being overwhelmed or wondering how you are going to get through the day – whether it’s the consults that keep coming in, the clients who keep calling or that patient that was stable and is rapidly deteriorating right at the end of your shift. Take some time to reflect back on these moments to understand your stressors and write them down. It can be helpful to identify, name and acknowledge them.
These are different for everyone but some common ones include an increased heart rate, sweaty palms, maybe your tone in your voice changes or shakes, or that feeling that you want to shut down. Understanding your signs can be helpful to identify when these come up for you, so that you can implement strategies sooner rather than later.
Many of us may think of mindfulness as sitting cross legged and trying to completely blank out your mind. What is important to acknowledge as there are many ways to practice mindfulness including walking outside without your headphones and pay attention to your surroundings, yoga and meditation are common but these do not resonate with everyone. What is important is to find something that works for you, that you can incorporate into your daily routine and stick with it.
How many of us schedule in some time just for ourselves each week? As veterinarians we are very good at making time for everyone else, but not necessarily ourselves. Take some time each week doing an activity that is just for you and brings you joy.
With the last 2 years and COVID our normal social habits have been hindered and we have needed to adapt. It is so important to have human connection outside of your workplace – whether it is connecting with family, friends, your uni mates or members of your local community. If you have not connected with someone in a while – reach out and check in with them. Now more than ever it is important for us to have a sense of connection and community.
Dr Liz Napier BSc (PV), DVM, MANZCVS Mental Health
Often when the new year comes around it triggers us to sit down and think about our goals. However, we often get busy or other things come up and your goals can be forgotten. Takev some time now to write out some long and short term goals –and write them down! You are more likely to achieve your goals if they are written down (and make sure they are somewhere you can see them).
These will be individual to you, and should be practical and simple for you to carry out when you identify a stressor, or you notice some symptoms of stress. Some examples can include: deep breathing – take 5 deep breaths in and out, giving yourself the space to focus on your breath, change you space – step outside or into a different room, go and make a cup of tea, find a cute puppy or kitten in the clinic and give it a cuddle.
So much of what causes us stress is out of our control. Write down or name you stressors, and then look at what is truly in your control. If it is in your control then look at strategies for change. If it is not in your control take the time to acknowledge this – examples can be owner finances or delayed presentation of a patient until the animal is really critical. We have all been through these situations and probably taken on the limitations of the client as our own. As veterinarians we are here to help, so identify what we can do, what we can control and re-direct your focus there.
What is wonderful about being a veterinarian is the collaborative nature of our profession. If you are experiencing something, chances are someone else has gone through something similar before. It is so important to speak up, let people know where you are struggling and what they can do to help. It is important to create a safe space in your workplace to allow for debriefing between colleagues – try and think about how you could create this in your workplace.
If you find something that works for you then share it. Sharing ideas and having open conversations within our profession will create a psychologically safe space, helping us to be happier and more productive at work, and making it easier to switch off when we have down time.

If you want to know more about mental health, the good news is there is so much information and resources out there. Increasing your mental health literacy and knowledge is a great starting point.
Website with excellent resources for diagnosis, treatment and prevention of mental illness.



Dispelling the myth that vulnerability is weakness and reveals that it is our most accurate measure of courage.
Maybe you should talk to someone Lori Gottlieb
A therapist shares wise and witty insight into clinical observations of her patients, but also her own personal journey in therapy. Gottlieb explores psychological transformation, loss and grief and discovering meaning in life and work.

‘Calm’ app with a collection of meditations, anxiety and stress management, sleep strategies and mental fitness.




1300 726 306
1300 687 327
Counseling Service available to AVA members, the vet professionals that work for them and family members – available 24 hours, 7 days a week.


Dr Elizabeth Napier will be running both face-to-face and online courses in 2023.
The Standard Mental Health First Aid course will teach participants how to provide initial support to other adults who may be experiencing a mental health problem or mental health crisis until appropriate professional help is received or the crisis resolves, using a practical, evidence-based Action Plan.


Back in 2014, our dean, Professor Kym Abbott, took a shrewd risk and asked if I would be interested in starting up a veterinary alumni group for our vet graduates. It was indeed a honour to be asked because I have been on the journey with all of you, our amazing graduates. However, I was not sure what it entailed but I did know some things. I wanted an alumni organisation to represent everyone who graduated as a vet from our school, for all alumni to feel part of a supportive network of like-minded people, to ensure everyone feels part of a familiar community, to take care of our grads that may have fallen on hard times and to support mental health. I wanted us to have some CPD, pull together a newsletter, and to meet, share stories and reminisce and for graduates to take up the role as mentors to our new students coming through.
Then an angel in the form Carolyn McLean from UA Alumni relations came on the scene and then things started moving along. We decided the way to go was to set up a committee of graduates to push forward with a UA of alumni network and so we did; mostly pressganged graduates with Claire MacRae (Class of 2013) at the helm and Mary McQuillan (Class of 2016) organising us all, and being cajoled by Carolyn to develop terms of references for the network and committee.
So, I reached out to the UA Alumni relations. Nothing happened despite many conversations. Undaunted, I pursued other avenues to connect with you. There seemed to be some traction with some students and graduates on the idea so in December 2016 with the help of newly qualified Hamish Burns (Class of 2016), we set up a FB page, and we called it the Roseworthy Veterinary Alumni FB page. It felt like we were up and running and at least we had some social media presence. Slowly but surely, we invited alumni to join this private group so we could share some news but also share jobs/residencies/internships etc and keep an eye on people and celebrate some good things.
The network was formed which meant we could get a website and a bank account. Carolyn knew about some grants and we duly received one to run our first major alumni driven reunion at the Gallery in Adelaide in 2021. Since then, things have moved quickly. Claire, as busy as ever, stood down as President and Manhei Ma (Class of 2014), the new President has become a force of nature with a proactive and passionate committee. CPD has been organised; we have a great new motif. Mental health support has been developed, a new reunion has come and gone all of which I am able to share with you in this, our very first newsletter.
So we are moving along nicely now – remember this network is for you, all of you who want to stay connected with your alma mater. Long may it continue to thrive!
What another great year– our first cohort of Animal Behaviour students graduated this year and the latest Vet Bioscience students and 9th cohort of DVM students. It was a real privilege to be part of the graduation ceremony as a proud lecturer but also for this once a PhD graduate myself.

The new semester is as busy as ever – five programs are running with the first cohort of Veterinary technology students now into their final year on rotation. Sadly, we have lost a lot of staff in the new restructure which means our school now sits under the new Faculty of Science, Engineering and Technology (formerly we were in one of five faculties: the Faculty of Sciences).
Luiz Santos, Kirsty Gallagher, Lynette Bester have all sadly moved on. Another huge loss is Peter Hill who has been at the school since we started and has taken position at SASH. Our Head of School for seven years, Professor Wayne Hein has also stepped down. Wayne has guided us through all sorts of trials and tribulations including COVID. Often a thankless job especially over the last two – three years as austerity hit following COVID, we thank him for his dedication and passion. We all wish him well in his retirement which is so well deserved. On the 1st August we welcomed Professor Rob Woodgate who has take over the reins. You may have met Rob at the last reunion. He comes from Charles Sturt University in Wagga Wagga where he had been heading a large school there which includes a veterinary campus. Welcome Rob!!




 Professor Rob Woodgate New Head of School
Professor Rob Woodgate New Head of School
Within the Alumni Committee, mid this year we farewelled our much loved Carolyn McLean who has been a driving force in helping our Alumni community grow and supporting the Committee in achieving our yearly calendar of events. She has been thrilled to work alongside the Committee and the passion and drive to engage alumni which has seen it grow and a quality program created that reaches alumni locally and around the world. The Alumni team has undergone some recent changes. Cassie Llewellyn-Smith is the new Associate Director, Alumni Relations and Matt Bell has been appointed as the new Alumni Relations Coordinator for the Faculty of Science Engineering and Technology (SET). Matt will be supporting the RVA Network moving forward. Welcome Matt!
At the end of this year we also farewell committee members Mitchell Graham, Claire MacRae and Daniel McGilp who have dedicated their time to the RVA. We thank each of them for their valuable roles they have played in the RVA Committee and wish them all the best!


In 2021 the Australian Veterinary Association (AVA) conducted its 6th workforce survey of veterinarians in Australia and produced two reports. The remuneration analysis provided great insight into the landscape of how veterinarians work in Australia and how they are remunerated. This report provided the inspiration for the RVA South Australian Workforce Survey.
The goals of which were:
1. To explore the fields in which South Australian veterinarians are employed

2. To characterise on what basis South Australian veterinarians are employed in and how many hours they work each week
3. To determine how South Australian Veterinarians are remunerated
A total of 266 veterinarians responded to the survey, which represents 31.6% of all veterinarians in the state and allowed the data analysed to be statistically significant at a 95% confidence interval.



The survey can be accessed via the QR code or on our social media channels.
The results of the survey were intriguing and provide important information regarding the state of the profession in South Australia in 2022. Our hope for this survey is that it will allow veterinarians to determine where they stand in the profession and bring about positive change for working conditions in the future.
The RVA thanks you for your participation in this survey and looks forward to your continued cooperation in data gathering events in the future.
Figure 1: Some of the data collected from the survey









Thank you to our speakers for sharing their knowledge and advice to our veterinarians, alumni, nurses and students.



Thank you to all those who joined us in person or via zoom! We hope you gained knowledge which you have been able to bring to your daily workplace.

Thank you to our General sponsors this year for supporting the RVA program.Dr Andrew Whale The opportunities for rural vets Dr Gary Turnbull (Lincoln Institute) Developing a Financial Mindset Roseworthy Veterinary Alumni









This year Dr Elizabeth Napier (2014 alumnus), RVA’s mental health advocate, ran our first MHFA course. 12 particpants from across Australia attended via zoom and are now all qualified Mental Health First Aiders.

Congratulations! We are stoked that more of our graduates will be able to provide mental health support to those around us.
Our annual social event was yet again a great success ! Seeing our numbers double from last year with attendance from alumni across all graduated year levels, DVM students, academics, and Head of School. This year we had the addition of an ‘icebreaker’ and photobooth creating a wonderful atmosphere for all to reconnect and meet new alumni within our community.

Precursor immune mediated anemia (PIMA) is an uncommon cause of anemia in dogs and cats. The pathogenesis involves immune-mediated destruction of erythrocyte precursors within the bone marrow (rubriphagocytosis) as opposed to destruction of mature erythrocytes in peripheral blood, which results in the anemia appearing nonregenerative.
Preliminary diagnostic steps include a CBC/ biochemistry panel and demonstration of a persistent, moderate to severe non-regenerative anemia, often without other cytopenias. Extra marrow causes of anemia that could be excluded with these initial results include an anemia of inflammatory disease, anemia of chronic renal disease, iron deficiency anemia, and endocrine disease (e.g. hypothyroidism, hypoadrenocorticism).
Clinicopathological findings for a small number of PIMA cases were recently documented. (Lucidi et al., 2017). Presenting clinical signs are non-specific, with lethargy and hyporexia most commonly reported. Affected dogs ranged
Figure 1: A left shift in erythroid precursors, with increased numbers of early-stage precursors (rubriblasts – white arrow, rubricytes – black arrows) and a relative paucity of later stage precursors (metarubricytes – arrowhead).
from 1-15 years of age with no obvious breed disposition (Lucidi et al., 2017). Hematological findings other than a moderate to severe non-regenerative anemia (of at least 5 days duration) were variable; neutrophilia or mild neutropenia, lymphocytosis or lymphopenia were documented. Spherocytes are generally absent and dogs are rarely coomb’s positive. Mild hyperbilirubinemia may be seen (Lucidi et al., 2017).
Bone marrow examination is required to confirm the diagnosis and to rule out other causes of nonregenerative anemia (e.g. primary or metastatic neoplasia, infectious causes, or histiocytic disorders, though these are often associated with bicytopenia or pancytopenia). Bone marrow findings are variable depending on the stage of erythroid precursor being destroyed.
Selective rubriphagocytosis helps confirm the diagnosis but is not always seen. Varying degrees of myelofibrosis may or may not be present (Stokol, Blue and French, 2000; Lucidi et al., 2017) and this could have prognostic significance.
Dogs with significant myelofibrosis may be less likely to respond to immunosuppressive therapy, though its presence does not exclude remission occurring (Lucidi et al., 2017). Both marrow aspiration and core biopsy collection are recommended (with a CBC from the time of marrow sampling).
Aspiration samples provide better evaluation of cellular detail and

detection of rubriphagocytosis, while core biopsies help detect and quantify any myelofibrosis. An aspiration sample will likely provide more information overall and should be prioritized. However, if there is significant myelofibrosis then obtaining a diagnostic aspirate may not be possible, and a core biopsy will be relied on for diagnosis.
Median time for response to treatment is approximately 1 month, with median remission times of approximately 2 months (Lucidi et al., 2017). Prednisolone may be used alone or in combination with cyclosporin or azathioprine. Blood transfusions may be required (Stokol, Blue and French, 2000; Lucidi et al., 2017).
Patients may require long-term therapy and caution should be exercised when tapering therapy. Rapid tapering could lead to relapse and some dogs may subsequently not respond to re-commencement of therapy though immunotherapy may be able to be withdrawn eventually (Stokol, Blue and French, 2000; Lucidi et al., 2017).
PIMA cases have also been documented in cats. It may present at any age though most cases were seen in cats less than 3 years of age, and there is no apparent breed disposition (Black et al., 2016). Lethargy and hyporexia are commonly reported clinical signs. Unlike in dogs, additional cytopenias (in particular neutropenia) were not uncommon, and half of the cases tested were Coomb’s positive (Black et al., 2016). A lymphocytosis may also be present (Winzelberg Olson and Hohenhaus, 2019).
Affected cats were FeLV negative. While FeLV is rarely seen in South Australia, I would still recommend
determining FIV/ FeLV status as these viruses have been associated with non-regenerative anemias (Harvey, 2012). Bone marrow findings are similar to dogs, though myelofibrosis may be more uncommon in cats (Black et al., 2016).
Treatment involves glucocorticoid therapy, additional immunosuppressives (e.g. cyclosporin, chlorambucil) and blood transfusions may be required (Black et al., 2016). Any concurrent neutropenia and/or thrombocytopenia is also expected to respond to immunosuppressive therapy reflecting immune mediated destruction of multiple cell lines (Black et al., 2016).
Median response times were around 1 month (12-42 days), some cats did not respond to treatment. Relapses were seen with tapering prednisolone doses though these patients responded to subsequent dose increases. Eventual withdrawal of treatment may be possible (Black et al., 2016).
While uncommon, Precursor Immune Mediated Anemias should be a differential when there is a persistent, moderate to severe nonregenerative anemia. Extra-marrow causes of anemia must be excluded with clinical findings and routine laboratory testing, and bone marrow examination is recommended to confirm the diagnosis.
Black, V. et al. (2016) ‘Feline non-regenerative immunemediated anaemia: features and outcome in 15 cases’, Journal of feline medicine and surgery, 18(8), pp. 597–602.
Harvey, J. W. (2012) Veterinary hematology : a diagnostic guide and color atlas, Veterinary hematology : a diagnostic guide and color atlas. St. Louis, Mo: Elsevier/Saunders.
Lucidi, C. de A. et al. (2017) ‘Histologic and cytologic bone marrow findings in dogs with suspected precursor‐targeted immune‐mediated anemia and associated phagocytosis of erythroid precursors’, Veterinary clinical pathology, 46(3), pp. 401–415.
Stokol, T., Blue, J. T. and French, T. W. (2000) ‘Idiopathic pure red cell aplasia and nonregenerative immune-mediated anemia in dogs: 43 cases (1988-1999)’, Journal of the American Veterinary Medical Association, 216(9), pp. 1429–1436.
Winzelberg Olson, S. and Hohenhaus, A. E. (2019) ‘Feline non-regenerative anemia: Diagnostic and treatment recommendations’, Journal of Feline Medicine and Surgery, 21(7), pp. 615–631.

The approach to working up these cases is actually very logical, and in most instances an accurate diagnosis and good outcome is able to be obtained.
Chronic enteropathies (which may manifest as chronic diarrhoea, or vomiting and diarrhoea +- hyporexia/anorexia) are a commonly encountered and sometimes frustrating disease entity in small animal practice, with a reported prevalence of between 1 and 20% depending on the study and centre(Dandrieux and Mansfield, 2019).
1. Baseline CBC/ Biochemistry is recommended in all cases of chronic diarrhoea. This is to screen for causes of extra-gastrointestinal disease such as liver disease, renal disease, electrolyte imbalances (ie hypoadrenocorticism), and also gives us an indication of if there is more severe disease such as a protein-losing enteropathy or chronic blood loss
2. Basal cortisol: this is used as a screening test for atypical Addison’s disease and is recommended in all cases of chronic gastrointestinal disease. A value of >55nmol/L will accurately exclude atypical Addison’s disease(Bovens et al., 2014), however values lower than this will need an ACTH stimulation test for confirmation. The secretion of cortisol is pulsatile, so an isolated low cortisol is not enough for diagnosis of the disease
3. Serum cobalamin and folate: cobalamin (Vitamin B12) is absorbed from the terminal ileum and a low concentration is indicative of significant disease in this region. Until Vitamin B12 is supplemented, the primary disease process will be difficult to completely control. A high folate level in combination with a low Vitamin B12 level is suggestive of small intestinal bacterial overgrowth
4. Trypsin-like immunoreactivity (TLI): low levels are diagnostic of exocrine pancreatic insufficiency. While there are often telltale signs of EPI in dogs (weight loss, ravenous appetite, voluminous pale coloured stools), it is often still prudent to include this test in a chronic diarrhoea workup
Diet-responsive enteropathies are very common in dogs, with a reported prevalence of around 60-70%(Kawano et al., 2016).
Which diet is selected first often depends on a number of factors, including clinician preference, the presence of large bowel signs (ie colitis) vs small bowel signs, palatability of the diet and food preferences of the dog.
For dogs with signs of colitis (ie tenesmus, mucoid stools, haematochezia, frequent defecation), my preference is to start with a diet like Hills Gastrointestinal Biome. This is not a novel protein diet, but is enriched with pre and probiotics and soluble and insoluble fibres and is designed to help restore a healthy balance of microflora in the gut.
For dogs where this is unsuccessful, or who are exhibiting more small bowel signs, then an elimination diet such as a hydrolysed protein diet or a novel protein diet is recommended.
I personally have had good success with using Purina H/A which is a soy-based hydrolysed protein diet (many of the other commercial diets available still contain hydrolysed poultry by-products).
Prime 100 make a good range of novel protein diets (Crocodile/ Tapicoa, Kangaroo/Potato, Pea/ Hemp) and often these are a good option for the fussier patients who refuse to eat dry food.
With all diet trials, the new diet must be fed EXCLUSIVELY for at least 2 weeks (and preferably 4). If there is successful response, the patient may be left on the new diet indefinitely, or the owner can experiment with food challenging the patient.
A number of dogs have antibioticresponsive diarrhoea, or have occult parasitism which contributes
to their clinical signs. The use of faecal floats, cultures and PCRs is controversial because a. parasites often shed intermittently, and b. many normal dogs are positive for bacteria such as Clostridium perfringens, so interpreting the results of this can be challenging.
I tend to reserve faecal testing for outbreaks of shelter or breeder diarrhoea, where there are genuine concerns for contagious infectious diarrhoea such as Salmonella or Campylobacter sp.
It is recommended that all cases of chronic diarrhoea undergo a treatment trial with metronidazole (10-15mg/kg PO BID for 2 weeks), and a course of fenbendazole (50mg/kg PO SID for 3 days), prior to consideration of further diagnostics.
gastroscopy and colonoscopy), laparoscopically and open celiotomy. Endoscopic biopsies are pinch biopsies of the mucosa (+- submucosal layers), and only the stomach, duodenum, ileum and colon are able to be accessed. If there is suspicion for significant disease affecting the jejunum, or affecting deeper layers of the gut then this may not be an appropriate biopsy technique. Full thickness biopsies are able to be obtained via laparoscopic and open celiotomy and this is utilised when there is concern that endoscopic biopsies may not be diagnostic, or when endoscopy is not available. There is obviously more downtime and risk of dehiscence with full thickness biopsies, and sometimes treatment such as high dose steroids may need to be withheld until there has been time for adequate wound healing.
Intestinal biopsies allow us to diagnose conditions such as idiopathic inflammatory bowel disease, granulomatous enterocolitis, and infiltrative neoplasia such as small cell lymphoma.
Ultrasound is the preferred method of imaging for assessment of the gastrointestinal tract. This is recommended prior to biopsy, because it may influence the types of biopsies that we recommend, depending on the location of the disease. It also screens for intestinal masses and other pathology which may be managed differently.

Note that a normal ultrasound does not preclude the presence of microscopic changes and ultimately intestinal biopsies may be required.
There are a number of methods for obtaining biopsies, including endoscopically (a combination of
In some cases, we do not have the luxury of time to undertake treatment trials and full diagnostic workup prior to proceeding to biopsies. In cases of protein losing enteropathies, severely hyporexic patients, dramatic weight loss or otherwise very debilitated animals, it is recommended to proceed to imaging and biopsy sooner, and treatment trials can be undertaken once a diagnosis has been obtained and the patient is more stable.
BOVENS, C., TENNANT, K., REEVE, J. & MURPHY, K. F. 2014. Basal serum cortisol concentration as a screening test for hypoadrenocorticism in dogs. J Vet Intern Med, 28, 1541-5.
DANDRIEUX, J. R. S. & MANSFIELD, C. S. 2019. Chronic Enteropathy In Canines: Prevalence, Impact And Management Strategies. Vet Med (Auckl), 10, 203-214.
KAWANO, K., SHIMAKURA, H., NAGATA, N., MASASHI, Y., SUTO, A., SUTO, Y., UTO, S., UENO, H., HASEGAWA, T., USHIGUSA, T., NAGAI, T., ARAWATARI, Y., MIYAJI, K., OHMORI, K. & MIZUNO, T. 2016. Prevalence of food-responsive enteropathy among dogs with chronic enteropathy in Japan. J Vet Med Sci, 78, 1377-80.
Copyright © 2022. RVA. All rights reserved.
Since the early days of veterinary medicine, the teaching philosophy of “see one, do one, teach one” has been adopted in the training of countless clinicians. This applies to the field of veterinary neurosurgery where the operating theater has served as the classroom for learning new surgical procedures. Neurosurgery residents, however, face a steep learning curve during their training. Intraoperative challenges include a narrow operating field-of-vision, time-sensitive procedures, and inability to visualize anatomical landmarks (Pelargos et al., 2017). Most neurosurgical procedures are also performed near delicate neural structures leaving a very low threshold for error (Pelargos et al., 2017). In a study by Fink et al. (2017), veterinary residents required at least ten exposures to a hemilaminectomy before grasping the fundamentals of the procedure. Furthermore, surgeries performed by veterinary surgical residents were associated with prolonged surgical times (Fink et al., 2017). Educating a resident may, therefore, be at the expense of increased surgical risk. In an age of emerging medical technologies, new methods should be leveraged to improve resident training.
Image 1: Intraoperative view of 3D reconstructed skull of patient diagnosed with intracranial neoplasia.
One such technology is augmented reality (AR). AR superimposes a threedimensionally rendered object into the real environment (Contreras López, Navarro and Crispin, 2019). In the context of neurosurgery, AR has the potential to integrate the key elements of preoperative image planning and intraoperative neuronavigation. At the Auburn University College of Veterinary Medicine,
 Devathansan DVM, MS, DACVIM (Neurology)
Devathansan DVM, MS, DACVIM (Neurology)
our team has developed an AR platform allowing the neurosurgeon to overlay a 3D-reconstructed anatomical image from an MRI or CT scan onto a live patient (or surgical field). This grants a neurosurgeon a real time “X-ray”-like view of the surgical field which includes deep anatomical structures (such as the brain or spinal cord) which typically require extensive surgical dissection to visualize. This augmented perception of a surgical site is proposed to minimize unnecessary tissue handling, inadvertent damage to neural structures and creates a minimally invasive neurosurgical approach (Pelargos et al., 2017; Contreras López, Navarro and Crispin, 2019). AR is also expected to increase a neurosurgeon’s spatial awareness of anatomical landmarks raising confidence during surgery (Pelargos et al., 2017). Ultimately, a major goal of our project is to create a teaching tool for training neurosurgery residents.

Neurosurgical training is one of many potential applications of AR. The use of AR has been wellestablished in other fields of medical education. In one of the largest applications of AR to date, Case Western Reserve University taught human anatomy to 185 firstyear medical students remotely during the height of the COVID-19 pandemic (Wish-Baratz et al., 2020). Survey results were positive with many students finding AR an effective way in learning anatomy (Wish-Baratz et al., 2020). In veterinary medicine, the use of AR is still in its infancy. This is likely due to cost, availability of AR devices as well as lack of expertise in software development. There are, however, several veterinary studies looking into the use of AR as an intravenous injection simulator, educational tool for cardiac and cranial anatomy and for laparoscopic skills assessment (Lee et al., 2013; Fransson et al., 2016; Christ et al., 2018; Little et al., 2021). As AR technology continues to evolve, it is likely to become more accessible to the veterinary industry. Ultimately, the use of AR has the potential to become an integral part of veterinary education.
Christ, R., Guevar, J., Poyade, M. and Rea, P.M., 2018. Proof of concept of a workflow methodology for the creation of basic canine head anatomy veterinary education tool using augmented reality. PloS one, 13(4), p.e0195866.
Fink, O.T., Boston, R.C., Wu, T., Brown, D.C. and Runge, J.J., 2017. The learning curve for veterinary surgery residents performing hemilaminectomy surgeries in dogs. Journal of the American Veterinary Medical Association, 250(2), pp.215-221.
Fransson, B.A., Chen, C.Y., Noyes, J.A. and Ragle, C.A., 2016. Instrument motion metrics for laparoscopic skills assessment in virtual reality and augmented reality. Veterinary surgery, 45(S1), pp.O5-O13. Lee, S., Lee, J., Lee, A., Park, N., Song, S., Seo, A., Lee, H., Kim, J.I. and Eom, K., 2013. Augmented reality intravenous injection simulator based 3D medical imaging for veterinary medicine. The Veterinary Journal, 196(2), pp.197-202.
Little, W.B., Dezdrobitu, C., Conan, A. and Artemiou, E., 2021. Is augmented reality the new way for teaching and learning veterinary cardiac anatomy?. Medical science educator, 31(2), pp.723-732. López, W.O.C., Navarro, P.A. and Crispin, S., 2019. Intraoperative clinical application of augmented reality in neurosurgery: a systematic review. Clinical neurology and neurosurgery, 177, pp.6-11. Pelargos, P.E., Nagasawa, D.T., Lagman, C., Tenn, S., Demos, J.V., Lee, S.J., Bui, T.T., Barnette, N.E., Bhatt, N.S., Ung, N. and Bari, A., 2017. Utilizing virtual and augmented reality for educational and clinical enhancements in neurosurgery. Journal of clinical neuroscience, 35, pp.1-4. Wish-Baratz, S., Crofton, A.R., Gutierrez, J., Henninger, E. and Griswold, M.A., 2020. Assessment of mixed-reality technology use in remote online anatomy education. JAMA Network Open, 3(9), pp.e2016271-e2016271.



This dish can be found in Ottolenghi Test Kitchen by Noor Murad & Yotam Ottolenghi
We all know that feeling as you finish writing the last of your notes. Finish work late after a tough day at the office, tummy rumbling and you are dreading having to go home and cook up something to soothe your weary soul. Desperately in need of comfort food that isn’t Uber Eats? Enter Yotam Ottolenghi. This middle eastern twist on a classic dish is easy-peasy mac ‘n’ cheesy, quick to make and an absolute delight to consume. Make it a staple recipe in your household and your life will be all the better for it! Experiment with different pasta shapes and different cheeses to find what works for you! To make this recipe vegetarian use non-animal rennet cheeses.
Unfortunately the recipe cannot be shared due to copyright reasons but can be found online in multiple locations including the guardian. com/food, food52.com and the happyfoodie.co.uk.

To drink alongside this rich and comforting dish requires something that will match the food but will also quench your thirst while making it. A riesling with a racy acidity is perfect to cut through the creaminess of the sauce but also complement the citrus elements within this delicious delicacy. I recommend the 2021 Pikes ‘Traditionale’ riesling from Clare. Not only is it made by Roseworthy Old Scholars Andrew and Neil Pike (Neil now retired), but it is one of Australia’s most celebrated rieslings. At a pH of 2.93 and only 11.5% alcohol, it is sure to hit the spot both while making and consuming the main course.
Available at any good bottle shop, Dan Murphy’s - $22.99.
So kick off your shoes, throw your scrubs on the ground and settle into the couch, glass of wine and bowl of mac ‘n’ cheese in hand. Enjoy alongside a trashy netflix drama, you’ve earned it.
Copyright © 2022. RVA. All rights reserved.
If you asked me when I graduated from DVM at Roseworthy 6 years ago if this is where I’d see myself now it would have been a big “heck no!”. I was well and truly done with study when I graduated and would have laughed at you if you’d said I was going to be primarily a sheep vet- but when the opportunity came knocking, I had to go for it and I’m glad I did!


It all started in 2019 when I was working at Livestock Logic in Hamilton as a bright eyed bushy tailed livestock veterinarian. We had a very knowledgeable clients base of farmers in Hamilton. They were running their commercial flocks as per industry guidelines and following lifetime ewe principles (that’s a course you can do as a farmer that teaches key skills such as body condition scoring, estimating food on offer and creating a feed budget for your ewes). Even though these guys were doing everything right they were still losing ewes over lambing each year and were finding it frustrating. Because of this we set out to find out exactly how many ewes were dying over that period and for what reasons.
The project quantified the typical losses during lambing on 51 commercial non-Merino sheep enterprises across southern Australia. Over a 2 year period, a team of us gathered histories on these properties and conducted post mortem examinations (PMEs) on just shy of 700 ewes. By the end of completing around 70% of those PMEs myself, I’d become quite handy at flaying a sheep and probably lost a good portion of my olfactory senses (for self-preservation purposes!). I’d question my sanity sometimes out in the pouring rain in the depths of winter straddling a gangrenous corpse with 20 more to get through but to be honest and at risk of sounding macabre, I loved it! It was so interesting finding out what had killed these poor girls and knowing that this project was going to lead to some practical findings to reduce ewe losses was always at the forefront. It was something you’d never normally get to do as no one calls you out to look at deaths over lambing- you often discuss it after the fact when it was too late to know what had gone on. The producers I worked with were absolute legends and so keen to learn too.
I’m in the midst of completing a professional doctorate at Charles Sturt University on the topic of ewe survival over the periparturient (lambing) period.

I’d say my biggest take home from this project was that dystocia was a bigger problem than we initially expected, and it wasn’t always obvious on visual inspection. In fact without doing PMEs you’d miss a diagnosis of dystocia in every second ewe that died from the condition.
We developed benchmarks for ewe survival that producers can target which has become a useful metric for farmers.
Looking deeper into causes of ewe death we were able to see which diseases could be virtually eliminated with good management. An example of this was the dorsal vaginal wall ruptures that showed up spectacularly in NSW flocks the year they got a very good autumn break and sheep were in excessive condition on excessive feed. If the sheep had of been managed for a more appropriate condition score these deaths could have been prevented.
The project has produced some resources for both sheep producers and vets, which are available on the MLA website - https://www.mla.com.au/research-anddevelopment/reports/2021/unlocking-the-keys-to-

ewe-survival/. These include a post-mortem protocol for vets (something you can print off and fill out when doing ewe PMEs), a lambing diary for producers and a summary factsheet. The final report for the project is also available through the same link, for those wanting more detail.
At the moment I’m in the writing phase of my doctorate, using the data we gathered from the project and applying a statistical method called Bayesian network analysis to decipher key risk factors that lead to these deaths over the lambing period. I should be all done and dusted by March next year. Doing applied research and learning skills in project management, statistical methods and writing research papers has been a bonus which is opening a lot of doors.




This project was delivered by Livestock Logic, in partnership with Pinion Advisory, Murdoch University and The University of Melbourne. The project was funded by Meat and Livestock Australia, working across Victoria, NSW, South Australia and Western Australia.








Exertional heat illness (EHI) is one of the oldest medical syndromes known to sports science, and whilst physiological differences exist between species, heat-related syndromes are similar amongst human and equine athletes.
In human athletes, exertional heat stroke (EHS) is among the top three causes of sudden death during competition, and in summer, it is the number one cause of athlete death in the USA. Similarly, equine hyperthermia and exertional heat illness (EHI) are ongoing welfare issues for all exercising horses especially considering the current global warming. All equine sport disciplines are under increasing criticism by the general public and animal welfare associations. When fatalities occur, audiences are quick to condemn sport and racing events and increasingly call for safeguarding wellbeing in sports horses. I share this public concern and am committed to improving competition conditions for all horses through effective temperature monitoring.

Clinical signs of EHI in horses are not always recognized and are manifested differently depending on the type of sport discipline. For example, endurance horses develop metabolic disorders and heat exhaustion due to long lasting effects of
thermoregulatory stress such as dehydration and electrolyte loss. On the other hand, high-intensity exercise horses such as racehorses develop EHI with predominantly neurological signs (abnormal mentation with irritability and progressing to disorientation and ataxia). §Both EHI and EHS may involve extensive organ and tissue injury and the pathophysiology is still not completely unravelled and understood. At present, little is known about the influence of core body temperature evolvement on hyperthermia in real time during different types of exercise performed in field conditions. Consequently, it is becoming increasingly important to establish appropriate policies regarding the detection and prevention of all types of heat stress. To address this welfare need, I conducted multiple studies focusing on continuous monitoring of core body and skin temperatures of sport horses with a detailed view of the individual variability of equine thermoregulation during field exercise and recovery. I believe my thermoregulation research results can have a worldwide impact on how heat stress is managed in real-life equine sport and racing conditions.
My groundbreaking use of the novel telemetric gastrointestinal (GI) pill successfully monitored the core body temperature during competitive field exercise. Evaluation of the GI pill (in vitro and in vivo) in horses during real-time field exercise revealed the GI pill was a non-invasive, practical, and accurate device for monitoring heat-related responses during different exercise intensities (Verdegaal et al. 2017). In a second study, the GI pill was applied to continuously monitor 13 endurance horses during 40, 80 and 100 km endurance competitions at moderate speed and compared to 12 trotters racing at top speed over 1540 m in a cool environment. Interestingly, the peak core body temperature was not significantly different between endurance horses and trotters
Figure 1: Intraoperative Line-graphs of temperature (°C; left y-axis, black line) and cumulated (CUM) net AUC (Area Under the Curve, °C x min; right y-axis, red line) over time (hours, h; x-axis) during exercise periods (grey blocks or blue and red blocks) and it’s recovery. Examples: left side, two graphs of endurance horses (horse 6 & 8), and right side, 2 trotters (horse 23 & 25).


(mean 39C), but the timing of the peak temperature differed. More specifically, endurance horses reached peak temperature at 75% of completion of 40 km of exercise. However, trotters reached peak temperature always during recovery at a mean time of 30 minutes post-exercise. In addition, the temperature in endurance horses returned to baseline within 60 minutes into recovery while in 30% of trotters, temperature was still higher than 39°C at the end of recovery. This finding has important practical implications for safeguarding a sport horse’s health and welfare. For example, one practical solution could be extending post-exercise cooling as well as continuous monitoring for up to 60 minutes. Since endurance horses are considered as ‘fit to continue’ competition when the heartrate (HR) is 60 or 64 beats per minute or below (AERA or FEI), the finding that mean temperature was still 38.8 ± 0.4°C at a HR of 60 bpm is of importance suggesting their core body temperatures were already significantly increased when starting the next 40 km endurance loop. The study allowed for grading the thermal load in exercising horses by calculating the area under the curve (AUC, C-overtime). Another essential finding of the study was that horses have very individual thermoregulatory responses which require highly accurate monitoring no matter what type of exercise is performed in the field. (Figure linegraph examples of 4 horses).
In another study, skin temperature was compared to the GI pill temperature. A large array of skin temperature methodologies are currently used in the field, mainly pre- and post-exercise at time points. The aim of our study was to evaluate if skin temperature could be used as a proxy for core temperature. The skin temperature was continuously monitored and evaluated using an infrared monitor during a real-life endurance competition. Importantly, there was no correlation between skin and GI temperature. This important finding suggests we cannot rely on skin temperature to reflect core temperature. Doing so may endanger an exercising horse’s wellbeing (Verdegaal et al., 2022).
These are the first studies using a GI pill in actual equine field competitions. The overall conclusion is that a ‘onesize-fits-all’ approach to monitoring methods cannot safeguard thermo-welfare. This is similar to recent research in human exercise and is important because it confirms the need for individual continuous monitoring, a key aspect which was recently emphasised in an interview with “TheHorse”.
This first joint-PhD between the University of Adelaide and Ghent University is the blueprint for further cooperation with Ghent’s Research Group of Comparative Physiology led by Prof. Catherine Delesalle. At this exciting point in time, I will be establishing my own international thermoregulation–heat stress research group in collaboration with Ghent and other universities. Another part of my PhD included several pilot studies which are ongoing thermoregulationassociated projects to be completed. These pilot studies including epidemiology in exertional heat stress in racehorses, electrolyte loss in endurance horses and metabolic disorders in national endurance rides and the effects on different body systems such as muscles and gastrointestinal tract (data have collected) (Verdegaal et al. 2015; Verdegaal et al. 2018). Get in touch if interested to join this exciting and vital research or if you wish to start a PhD project to improve our sport horses’ welfare!
Lesté-Lasserre, C. (2021) ‘How Horses Heat Up and Cool Down Varies Considerably’ interview with Lidwien Verdegaal, TheHorse. Available at: https://thehorse.com/1110733/how-horsesheat-up-and-cool-down-varies-considerably/ Verdegaal E.J.M.M., Farrugia J., Franklin S.H. Owner’s survey of electrolyte supplementation in Australian endurance horses, preliminary results. Oral presentation at 8th International Congress of the European College of Equine Internal Medicine (ECEIM), Utrecht, The Netherlands; Nov. 2015. Journal Veterinary Internal Medicine, 30, 3, 909. doi: 10.1111/jvim.13925. Verdegaal, E-L.J.M.M., Delesalle, C., Caraguel, C.G., Folwell, L.E., McWhorter, T.J., Howarth, G.S., and Franklin, S.H. (2017). Evaluation of a telemetric gastrointestinal pill for continuous monitoring of gastrointestinal temperature in horses at rest and during exercise. American Journal of Veterinary Research 78, 7, 778-784. doi: doi: 10.2460/ajvr.78.7.778
Verdegaal E.J.M.M. (Lidwien), Delesalle C., McWhorter T.J., Howarth G.S., McLeod K., Weaver S., Franklin S.H. Incidence and description of exertional rhabdomyolysis in endurance horses at a 160 km National ride in Australia. Oral presentation at International Conference Equine Exercise Physiology (ICEEP), Lorne, Australia, Oct. 2018; Comparative Exercise Physiology, 14, 1; S27.
Verdegaal E-L.J.M.M. et al. (2021). Continuous monitoring of the thermoregulatory response in endurance horses and trotter horses during field exercise: Baselining for future hot weather studies. Frontiers in Physiology 12. doi: 10.3389/fphys.2021.708737 – free access.
Verdegaal E-L.J.M.M., Howarth G.S., McWhorter T.J., and Delesalle C.J. (2022). Is continuous monitoring of skin surface temperature a reliable proxy to assess the thermoregulatory response in endurance horses during field exercise? Frontiers in Veterinary Science doi: 10.3389/fvets.2022.894146 – free access.
Copyright © 2022. RVA. All rights reserved.
Firstly, congratulations to Dr Tamsyn Stephenson, on the recent conferral of her PhD entitled “Pathology, coinfections and oncogenesis in South Australian koalas (Phascolarctos cinereus) and their association with koala retrovirus (KoRV)”.


Dr Stephenson’s research, supervised by A/ Prof Farhid Hemmatzadeh, Dr Natasha Speight and A/ Prof Lucy Woolford, provided an unique examination of disease association with koala retrovirus (KoRV), Chlamydia pecorum and Phascolarctid gammaherpesviruses, due to the presence of koalas negative for these pathogens in South Australia. In this study, 41% (89/216) of koalas tested positive for KoRV. KoRV-associated lymphoma cases were explored for gene expression where significantly upregulated oncogenes MYB, MYC/MYCL and FLT3 were possible candidates in the incitement of oncogenesis. C. pecorum was associated with Phascolarctid gammaherpesvirus and urogenital disease in female koalas. Two novel pathologies were also found in this necropsy cohort: pulmonary actinomycosis (Stephenson et al 2021) and hypertrophic osteopathy (Griffith et al 2021).
Secondary hypertrophic osteopathy was also recognised in a subset of koalas with pulmonary actinomycosis. Plain radiographical and computed tomography images demonstrated periosteal reaction on multiple appendicular skeletal bones in all cases, including scapula, humerus, ulna, radius, ilium, femur, tibia, fibula, metacarpus, metatarsus and phalanx. Periosteal surfaces of the metaphyses and diaphyses of long bones were thickened and roughened, and histologically characterised by bi-layered proliferation of well-differentiated trabecular bony spicules oriented perpendicular to the cortex (pseudocortices) and separated by vascular connective tissue, typical for hypertrophic osteopathy. Well characterised in domestic species and rarely reported in marsupials, this is the first radiographical and pathological characterisation of hypertrophic osteopathy in koalas, associated with pulmonary actinomycosis in all cases.



In this study, Stephenson describes 16 free-ranging and one captive koala from Mount Lofty Ranges examined between 2016 and 2019 with pyogranulomatous bronchopneumonia or lobar pneumonia, predominantly affecting the left caudal lung lobe (14/17, 82%), associated with actinomycosis. Bronchial resin casts studies of normal koala lungs suggest the predilection for the left caudal lobe supports aspiration as the most likely route of infection (greater laminar flow of air to this lung lobe). Histologically there was striking pyogranuomatous pneumonia with intralesional Splendore Hoeppli material and Gram-positive or Gram-variable, non-acid-fast bacilli. Bacterial 16S rDNA revealed novel Actinomyces species in four koala samples. Actinomyces spp. are commensals of oral microbiome and are associated with similar pulmonary pathology in other species.
Copyright © 2022. RVA. All rights reserved.
Behaviour is one of the best ways we can assess the welfare of an animal, and can be used to provide not just adequate but great welfare. Through understanding the science of how animals learn, we can help to adapt their behaviour in our human-centred world. This becomes even more critical for animals with behavioural problems, when failure to remediate these can result in the death of the animal.
One of the best examples of how behaviour matters in veterinary practices is Petra Edward’s PhD project on fear in dogs visiting veterinary clinics. Petra reported 14% of dogs in a worldwide survey experienced severe fear when visiting the veterinarian (Edwards et al. 2019). This can mean guardians don’t take their dog to the vet even when they are sick, or that they go to a different vet, so it’s important we do as much as we can to alleviate or prevent this fear. As a demonstration of the impact of the physical examination on dogs, Petra showed that in some dogs heart rate peaked at over 180 beat per minute during the examination. Not all dogs showed obvious behavioural signs of fear and so veterinarians could miss the dog’s reaction (Edwards et al. 2022). Petra recently wrote a fantastic blog on what we can do to help with an excellent infographic that can be used in waiting rooms at the bottom of the page (https://set.adelaide.edu.au/news/list/2022/03/17/ why-are-dogs-scared-of-the-vet-and-what-can-i-doto-help).


Ana Costa Goncalves has interviewed guardians who have recently brought home a new puppy as part of her PhD. Her findings demonstrate that at least in those she interviewed, people coped with the problematic
BVSc, BSc(Vet), PhD, MANZCVS(Animal Welfare), GradCert(Public Health), GradCert(Higher Education)
behaviours that puppies can show, such as biting and toilet training, very well. To help them to cope though took a village- family, friends, advice on the internet and time and physical resources (such as places to walk) were all brought into play. Puppies quickly became part of each family, and guardians often thought of themselves as puppy parents, demonstrating the strength of the human-dog bond.
Julia Henning is investigating play behaviour and welfare in cats for her PhD. In research that will be submitted for publication soon Julia is looking at predictors for how much guardians play with their cats, and the association between play and welfare in cats. Cat play can occur at inappropriate times too, and Julia and I co-wrote an article on why cats wake us at night with practical suggestions for what guardians can do to get a good night’s rest (https://theconversation.com/ why-does-my-cat-wake-me-up-so-early-and-whatcan-i-do-about-it-180959).
We can always increase our understanding of the behaviour of the animals we live and work with, and it’s a great privilege to work on projects that improve the lives of animals and humans. The COVID detector dog project with Dr Anne-Lise Chaber has been incredibly exciting and the potential to tap into the amazing scent abilities of dogs will expand in the future. Stay posted to hear more about some novel cognitive testing we are setting up at Roseworthy campus for dogs, the impacts of doggy dementia on older dogs and their guardians, and pet ownership in Australian veterans.
Chaber A-L, Hazel S.J., Matthews B., Withers A., Alvergnat G.., Grandjean D., Caraguel C. Evaluation of canine detection of covid-19 infected individuals under controlled settings (2022) Transbound Emerg Dis. 2022 Mar 22. doi: 10.1111/tbed.14529.
Edwards, P., Hazel, S., Browne, M., Serpell, J., McArthur, M., & Smith, B. (2019). Investigating risk factors that predict a dog’s fear during veterinary consultations. PLoS ONE, 14(7), 18 pages. doi:10.1371/journal.pone.0215416
Edwards, P. T., Smith, B. P., McArthur, M. L., & Hazel, S. J. (2022). At the heart of a dog’s veterinary experience: Heart rate responses in dogs vary across a standard physical examination. Journal of Veterinary Behavior. doi:10.1016/j.jveb.2022.03.003
My 2 dogs, Fergus and Rosie. Sadly we lost Fergus (the Labrador) late last year at 10 years old.
We know that a change in behaviour is often the first sign that an animal is unwell. While this is important, how animals behave is important in so many other waysDr Susan Hazel

The Roseworthy Alumni and Students Mental Health Fund (RASMHF) is a University of Adelaide endorsed charity created in September 2021 to provide support to our graduates, students and staff, fostering deeper connections through activities generating positive energy and hope. Above all, we want to encourage anyone within our interconnected network experiencing mental illness (in any of its different guises) to reach out, seek help and feel that they are not alone.
The fund can be used to support travel costs and gifts for invited speakers (which includes invitations to our Alumni to return to Roseworthy and share their experiences), food, beverages and event running costs, mental first aid training, and initial psychologist consult costs for any students experiencing both mental illness and financial hardship. Given our proximity to the Barossa Valley,
good food is a focus at our events!! RASMHF is supported by Royal Canin, AVSA, Australian Veterinary Students for Mental Health, the Roseworthy Wellbeing Group, and RVA.








In 2022, we have held three events on the Roseworthy campus. For our first lunchtime event, Dr Serena Hawes (2019 graduate and personal vet to the four Trott fur children) talked about her experiences as a student and graduate veterinarian with food provided by Barossa based Handmade Catering (https://www. handmadecatering.com.au/; https:// www.musque.com.au/).
For our first evening event, Royal Canin sponsored Dr Channy McGowan to come and share her experiences as a student and veterinarian, Garry Putland talked to us about Sophie Putland’s legacy and our very own Dr Manhei Ma talked about her mental health journey, career to date and introduced the students to the RVA. It was an incredibly moving and groundbreaking night, attended by over 70 students, staff and Alumni. Cupcakes were donated by Fred’s bakery in Williamstown
(https://www.facebook.com/ fredsbakerybarossavalley/) and a delicious vegan salad provided by Darlings Café in Tanunda (darlingscafebarossa.com).
For our final evening event our guest speakers were two more Alumni, Dr Liz Napier and Dr Balasz Lovrecz. Once again, it was a very moving night as both detailed their triumphs and tragedies in practice and provided some real world tips for new graduates. Finally, Roseworthy Revue was held in October. It was our 10th Anniversary so our Abba Tribute Band Bjorn on the Toilet went all out. As our major funding raising event AVSA raised over $4,300 for RASMHF during Revue and we also got to wish our first cohert of Vet Tech graduates all the best for the future.
Thanks especially to our RASMHF committee members Julie Berry (new School Manager), David Purdie, Susan Hazel, Janelle Trott, Claire Benstead (AVSMF founder), Carrie Arbon (Royal Canin student representative) and Wayne Boardman (ex officio). Also a huge thanks to Dr Sophie Browne (2014 graduate) for offering to be the RVA member on our committee.
Copyright © 2022. RVA. All rights reserved.
Eating out, getting outdoors (hiking, swimming, walking my dog), wildlife watching, travelling, hanging out with friends whilst pretending to work-out.
Too many.... Mister Sunshine’s, Tony Tomatoes, fermentAsian, Singapore House, Perryman’s Bakery.
If I could go back to my University days I would Revisit my anatomy notes more frequently....
My Australian passport! The more time I spend overseas, the more valuable this becomes! Although nowhere is perfect, we are so lucky in Australia and should never take it for granted.
I can’t get enough of ...
Infectious disease! And beautiful histopathology.
My husband, cat, and dog.
Something you are grateful for
An amazing support network of
Copyright © 2022. RVA. All rights reserved.
family and friends. I would not be where I am without them.
If I could pursue a different career I would…
Absolutely no idea! But I love veterinary sciences because it opens so many different career paths.

The most valuable lesson I have learned
Be persistent, rise to the challenge, welcome constructive feedback.
I cannot get through the day without
My morning coffee (sad but true).
Three words your closest friends would use to describe you
Determined, honest, amusing.
Feeling fulfilled in my work, whilst having a decent work-life balance.
So many things. Be proud, grateful, tenacious, adventurous, and have fun.
Small animal practice for 2 years, wildlife/shelter/ER practice for 1 year while concurrently completing a Masters of Conservation Medicine through Murdoch University, then a Zoo and Wildlife Anatomic Pathology residency/fellowship at Cornell University and the Wildlife Conservation Society (WCS) in New York. Currently a toxicologic
pathologist at Charles River Laboratories working on artificial intelligence decision-support tools.
Being accepted into the Cornell/ WCS anatomic pathology residency and my years as a resident.
2022 is the year after I passed boards and had a baby, so I am taking my time, growing in my new ‘grown-up’ job, learning how to balance work and life, and just generally enjoying life without study!
Hanging out with my family, the gym, a good book, TV series, movie, or walk outside.
Uprooting myself and my husband’s lives/career to move to the USA for my residency - could have been a disaster I guess? But it turned out to be the best thing we ever did.
I’m a bit on skinny and small side but I can remove a bison’s brain with a hand saw in surprisingly fast fashion.
Don’t lose sight of the big picture and spend less time worrying about seemingly major vet school dramasthis is good prep for real life!
If I were to collect a gold coin for the number of happily stunned people who hear my occupation, I would be sitting at the table alongside Elon Musk and Jeff Besoz. It is no secret that most veterinarians don’t use their hard earned degrees to find a job in the aquaculture industry. In fact, a study conducted by Adelaide’s very own Adele Feakes revealed that when it came to preferred animal species to work with after graduation, aquaculture was the lowest based on the 884 veterinary students who participated (Feakes et al.2019).
So what happened with me? I’d like to think that I am an independent sole that zags when the world zigs. Alas, that was not it. I was motivated to start drawing attention and awareness to the large deficits we see in aquatic animal health compared to other industries.
According to the yellow pages website there are a total of 34 Aquarium stores in the greater Adelaide region. In addition to this, Animal Medicines Australia released statistics on Australian pet ownership in 2019 that indicated 1 in 10 Australian households (37 fish per 100 people) keep fish, with an average of 8 fish per home. With an approximate population of 1.721 million in South Australia(767,267 households) this would equate to a pet fish population of over 600,000 fish in this state alone. That is over 600,000 sentient creatures to which owners have no local vet health professional currently in South Australia.
Many believe that fish owners aren’t inclined to seek veterinary advice but that just isn’t all the facts. This belief has stemmed from fish owners not having professionals to turn to when needed, which has conditioned owners to attempt to solve their own problems leading to an over and inappropriate use of key medications such as anti-parasitics and antibiotics. Those that suffer the most from this outcome are the animals themselves. The lack of research in the field of aquatic animal health means a deficit in quality scientific based information for scientists and veterinarians to lean on thus putting fish in the too hard to treat basket. But never fear, For Fish is here!

The goal of this business is to collaborate with institutions to close key knowledge gaps in this area and provide fish farmers and owners a point of call avoiding their


need to seek advice from ‘Doctor Google’. By using research and having access to real life cases there will be more opportunity to educate and work with fellow veterinarians or veterinary students encouraging their engagement with aquatic animal health. We are also hoping to embark on creating new strategies to improve fish husbandry in sustainable ways.
Animal Medicines Australia(2019) Pets of Australia, A National Survey of Pets and its People. [ebook] Newsgate Research, p.6. Available at: <https:// animalmedicinesaustralia.org.au> [Accessed 11 April 2022].
Feakes, A.M., Palmer, E.J., Petrovski, K.R. et al.(2019) Predicting career sector intent and the theory of planned behaviour: survey findings from Australian veterinary science students. BMC Vet Res 15, 27. https://doi.org/10.1186/s12917018-1725-4
















We acknowledge and pay our respects to the Kaurna people, the original custodians of the Adelaide Plains and the land on which the University of Adelaide’s campuses at North Terrace, Waite, and Roseworthy are built. We acknowledge the deep feelings of attachment and relationship of the Kaurna people to country and we respect and value their past, present and ongoing connection to the land and cultural beliefs. The University continues to develop respectful and reciprocal relationships with all Indigenous peoples in Australia, and with other Indigenous peoples throughout the world.